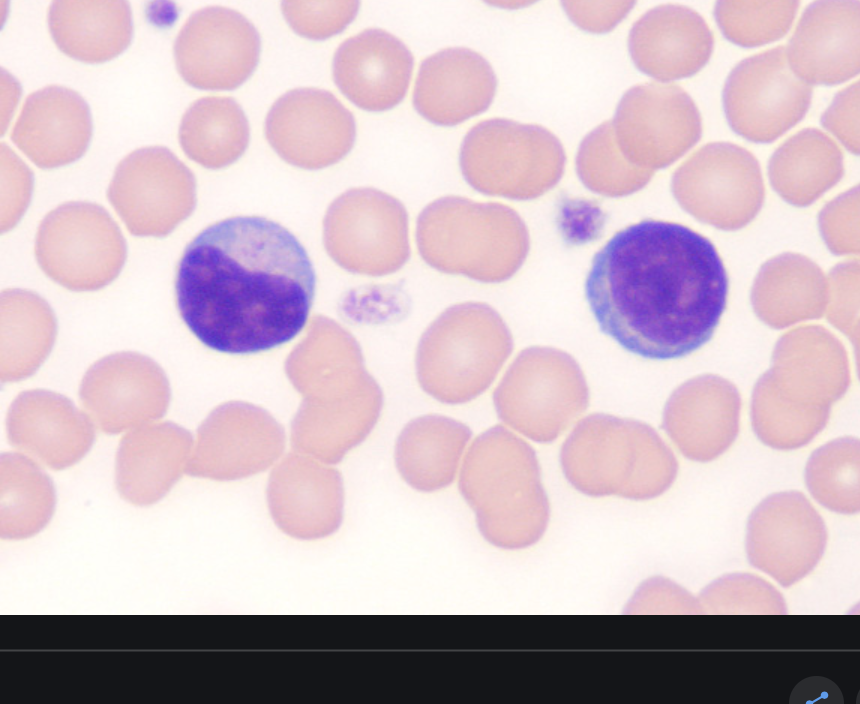

chronic inflammatory conditions are
incredibly common - not usually life threatening - debilitating (IBD and RA)
definition
prolonged inflammation with associated repair
characterised by
- Delayed onset - Variable duration (days years) - Variable appearances • No 5 cardinal features - Limits damage, initiates repair - Can cause debilitating symptoms
how does chronic inflammation arise
- Takes over from acute inflammation- if resolution not possible with acute inflammation
- Develops alongside acute inflammation- severe/persistent irritation
- Arises “de novo”- without preceding acute inflammation e.g. autoimmune conditions - Rheumatoid arthritis/ IBD/ diabetes
sometimes the proportion of cell types can
indicate diagnosis
which cells are indicative of rheumatoid arthritis
mainly plasma cells
which cells are indicative of chronic gastritis
mainly lymphocytes
which cells are indicative of of leishmaniasis (protozoal infections)
mainly macrophages
which cells are involved in chronic inflammation
- Macrophages 2. Lymphocytes- T/B cells 3. Mast cells 4. Eosinophils 5. Fibroblasts 6. Giant cells
macrophages in circulation
monocytes
macrophages once entering tissue space
macrophage (histiocyte)
features of macrophages
- big cells with a large cytoplasm - abundant foamy cytoplasm - slipper shaped nucleus - can look like a cancer cell

primary role of maxcrophage
phagocytosis - removal of pathogens/ necrosis/ debris - antigen presentation to immune system
secondary role of macrophages
- Also produce inflammatory mediators- controls and regulates inflammatory response
macrophages can look different depending on
what stimulus they are eating

lymphocyte features
- large, spherical stained nucleus
- thin rim of cytoplasm
- small
subdivided into T and B lymphocytes (cant distinguish appearance- have to use immunohistochemistry)
T lymphocytes
CD8+ (protein on surface)- Cytotoxic (MHC I)
CD4+- helper T cells (MHC II)
B lymphocyte
Mature into plasma cells
Produce antibodies (immunoglobulins)
Neutralises pathogens
plasma cell features
- Nucleus pushed off to one side (eccentric)
- Chromatin in the nucleus clumps into spheres (clock-face)
- Next to the nucleus there is slightly paler staining- peri- nuclear cytoplasmic clearing –> Golgi due to antibody synthesis

function of plasma cells
fully differentiated B lymphocytes
Produce antibodies
features of eosinophils
- 2 lobes (bilobed nucleus)
- cytolasm stains bright red and granular

why is the cytoplasm of an eosinophil bright red and granuklar
- Full of chemical mediators- Histamine, heparin and prostaglandins
- E.g. Release during hypersensitivity reactions and parasitic infections
features of fibroblasts/myofibroblasts
- webbed cytoplasm
- stretched nucleus

role of fibroblast/myofibroblast
- ‘Prolonged inflammation with associated repair’
- Role in generation and repair
- Produce and secrete and lay down collagen- helping to reconstruct tissue















